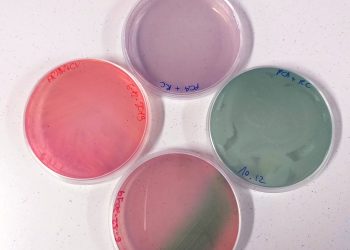
FUTURA. Il nostro terreno di coltura: una storia di patate, cavolo rosso e lockdown

Direttrice: Francesca Mulas
Nemesis Magazine è registrato al pubblico registro della stampa con decreto del Tribunale di Cagliari n. 14/2020
Editrice: Associazione culturale Terra Atra
Sede legale: Via del Sestante 5, 09126 Cagliari
Email: info@nemesismagazine.it